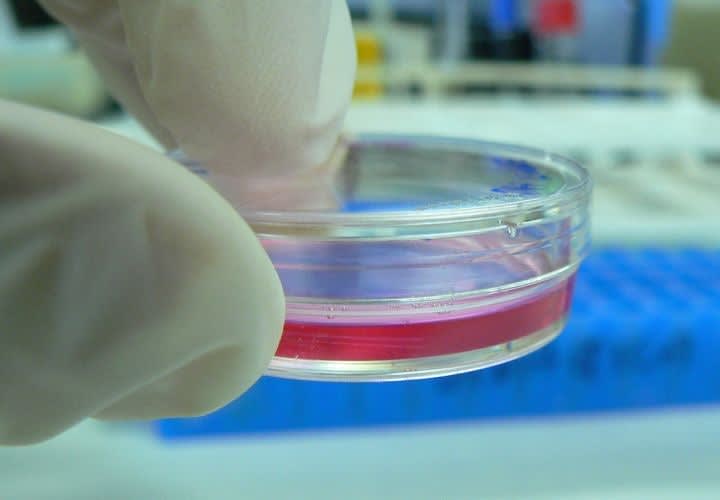
Catching Something Other Than the Bad Guy

Last month's unsealing of criminal information regarding the arrest of a 13-year veteran NYPD officer was, sadly, hardly an eye-opener. Det. Oscar Sandino allegedly violated the civil rights of three women through sexual misconduct while on duty and under color of authority. If culpable for the charges, Sandino is only the latest of many cops who got themselves in trouble in their pursuit of something other than a bad guy.
If I've always wondered about guys that would force themselves on women, I was even more amazed at the likes of those they imposed themselves upon. One deputy that I worked with had a beautiful, adoring wife—yet was extorting sexual acts on some of the ugliest hookers in our area. He ended up divorced and in prison (but one look at what Jesse James lost Sandra Bullock over is reminder enough that some guys will risk everything over anything).